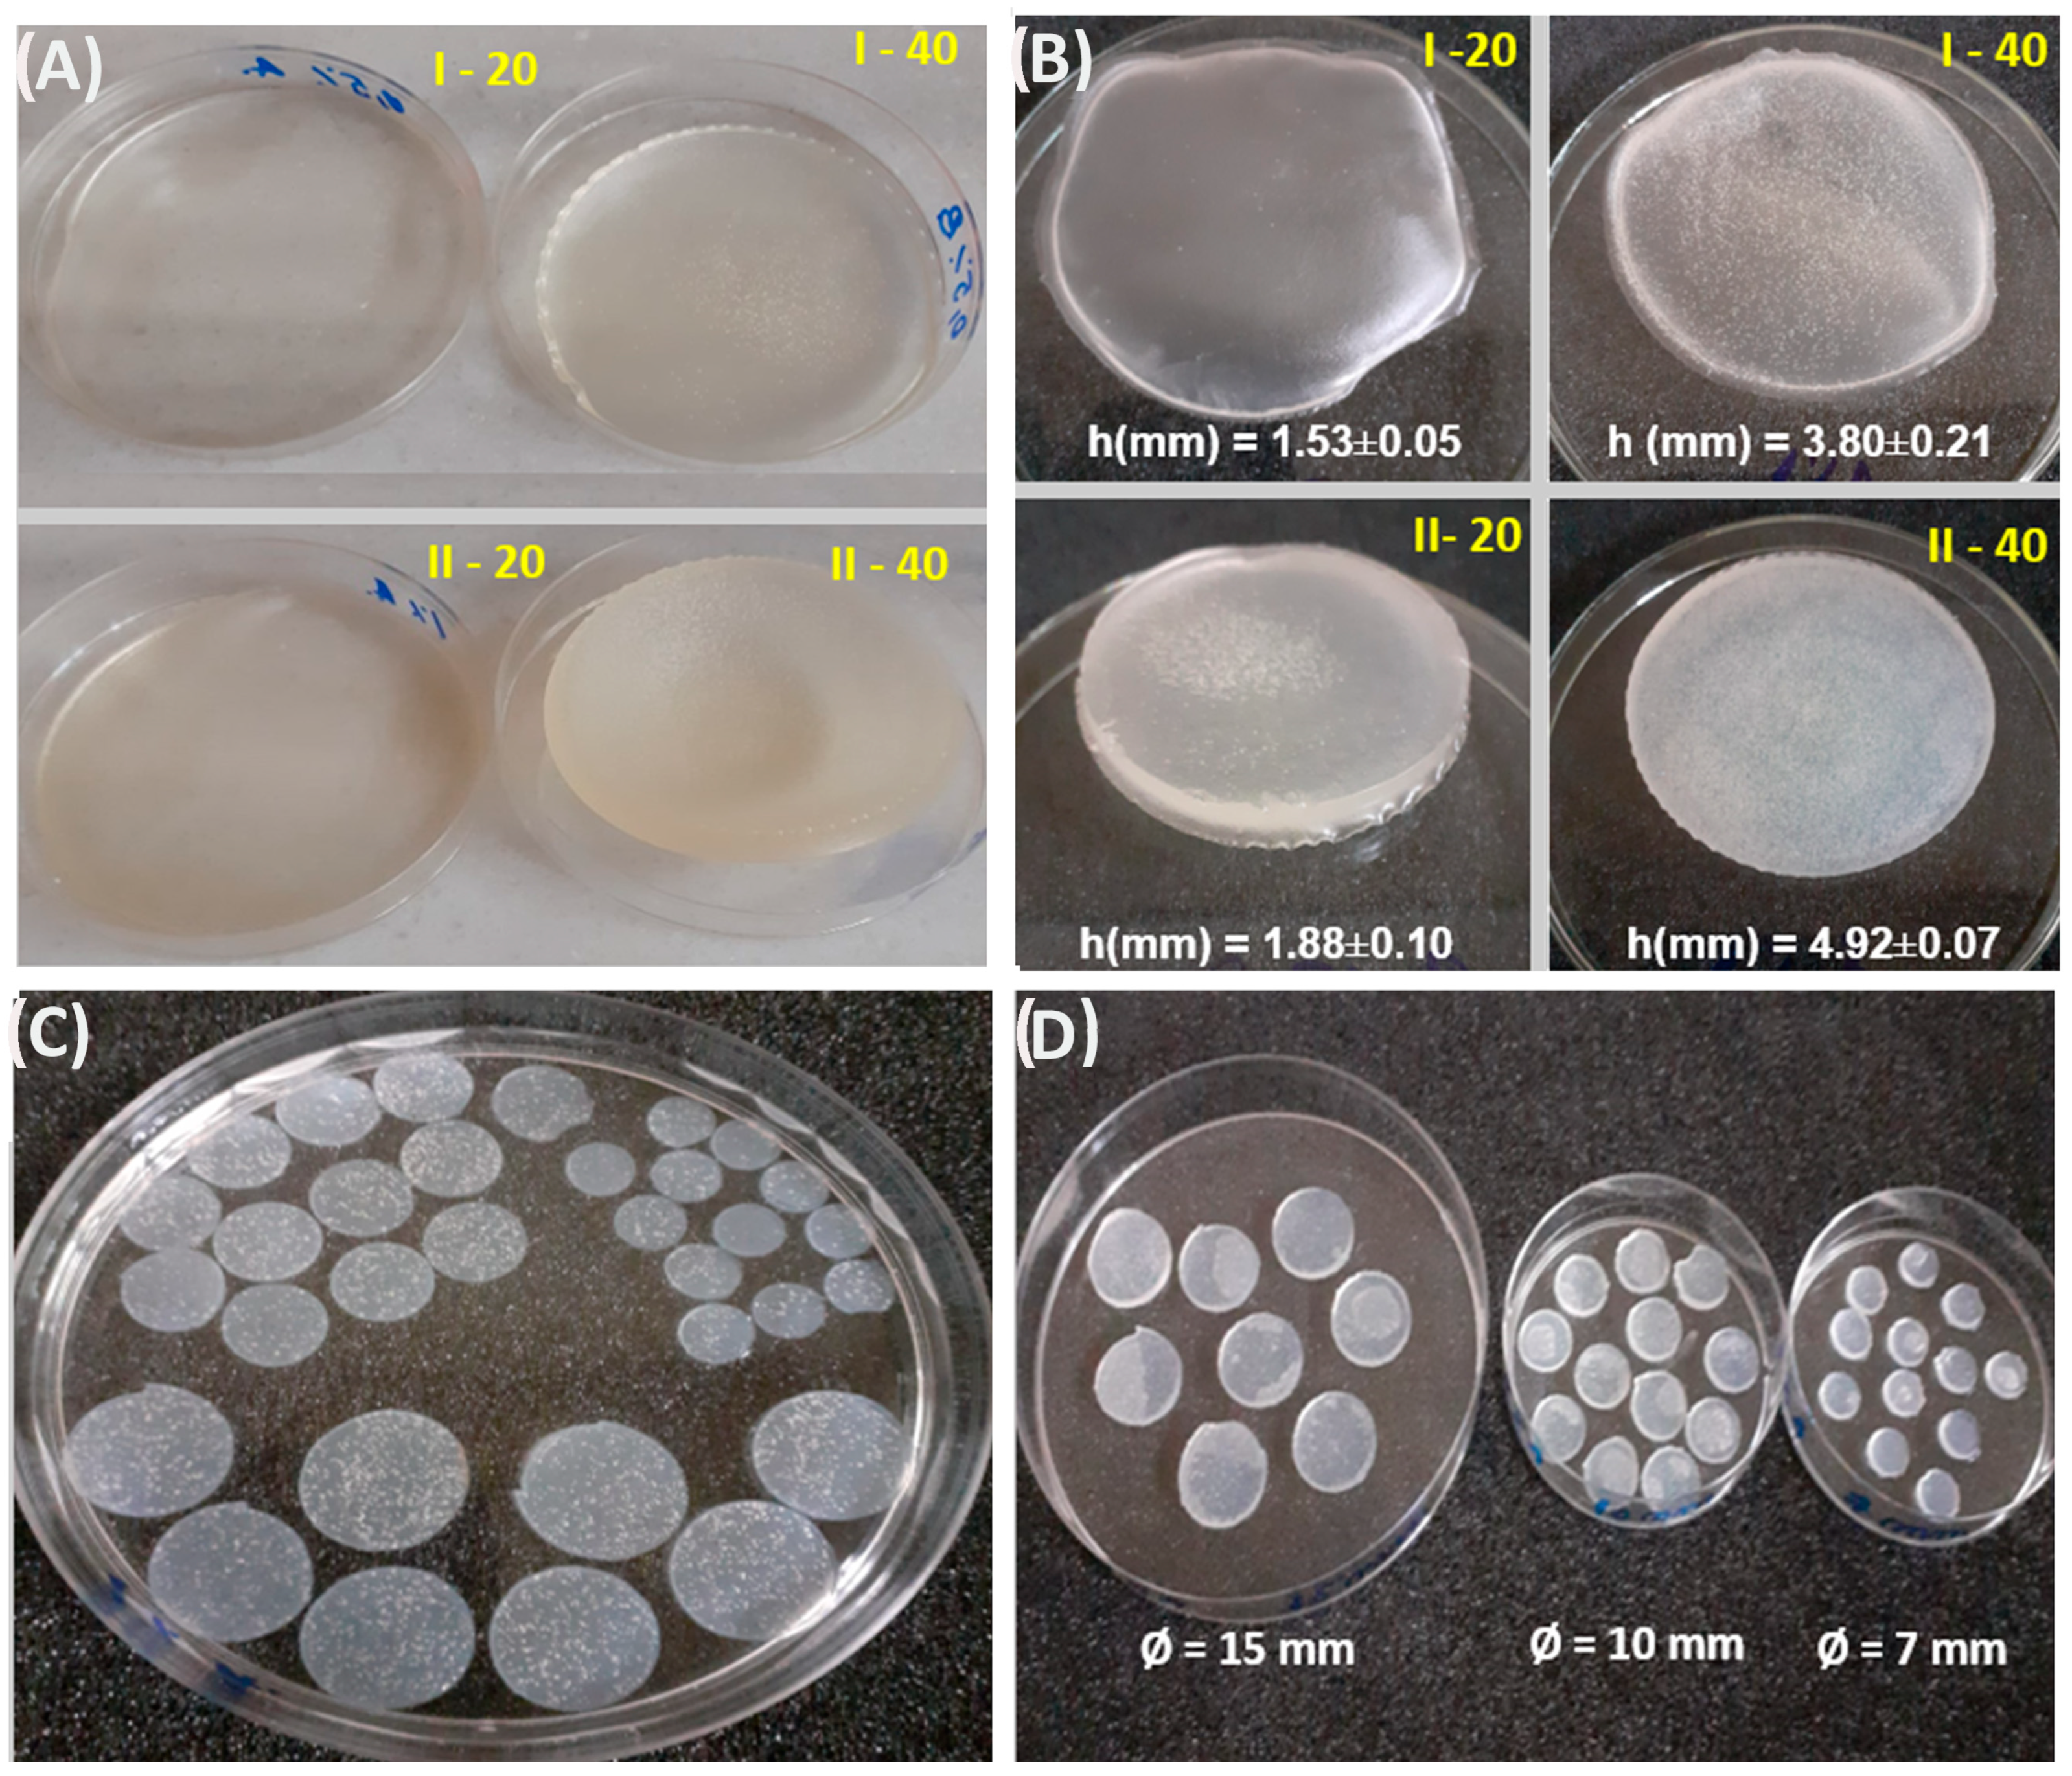
Gels 10 00588 g001

The Influence of the Structural Architecture on the Swelling Kinetics and the Network Behavior of Sodium-Alginate-Based Hydrogels Cross-Linked with Ionizing Radiation
Abstract
1. Introduction
2. Results and Discussion
2.1. Hydrogels Formation
2.2. Gel Fraction
2.3. Network Parameters
2.4. Swelling Behavior
2.5. Swelling Kinetics Study
2.6. Chemical Structure Analysis (FTIR)
2.7. Morphology of Hydrogels
3. Conclusions
4. Materials and Method
4.1. Materials
4.2. Sample Preparation
4.3. E-Beam Cross-Linking
4.4. Characterization
4.4.1. Gel Fraction
4.4.2. Determination of Network Structure
4.4.3. Swelling Behavior
4.4.4. Kinetics Study
4.4.5. Chemical Structure Analysis (FTIR)
4.4.6. Hydrogel Microstructure
4.4.7. Statistical Analysis
Author Contributions
Funding
Institutional Review Board Statement
Informed Consent Statement
Data Availability Statement
Acknowledgments
Conflicts of Interest
References
- Hoffman, A.S. Hydrogels for Biomedical Applications. Ann. N. Y. Acad. Sci. 2001, 944, 62–73. [Google Scholar] [CrossRef] [PubMed]
- Ullah, F.; Othman, M.B.H.; Javed, F.; Ahmad, Z.; Akil, H.M. Classification, Processing and Application of Hydrogels: A Review. Mater. Sci. Eng. C 2015, 57, 414–433. [Google Scholar] [CrossRef] [PubMed]
- Raza, M.A.; Jeong, J.-O.; Park, S.H. State-of-the-Art Irradiation Technology for Polymeric Hydrogel Fabrication and Application in Drug Release System. Front. Mater. 2021, 8, 769436. [Google Scholar] [CrossRef]
- Craciun, G.; Calina, I.C.; Demeter, M.; Scarisoreanu, A.; Dumitru, M.; Manaila, E. Poly(Acrylic Acid)-Sodium Alginate Superabsorbent Hydrogels Synthesized by Electron Beam Irradiation Part I: Impact of Initiator Concentration and Irradiation Dose on Structure, Network Parameters and Swelling Properties. Materials 2023, 16, 4552. [Google Scholar] [CrossRef] [PubMed]
- Stachowiak, N.; Kowalonek, J.; Kozlowska, J.; Burkowska-But, A. Stability Studies, Biodegradation Tests, and Mechanical Properties of Sodium Alginate and Gellan Gum Beads Containing Surfactant. Polymers 2023, 15, 2568. [Google Scholar] [CrossRef]
- Rosiak, J.M.; Ulański, P. Synthesis of Hydrogels by Irradiation of Polymers in Aqueous Solution. Radiat. Phys. Chem. 1999, 55, 139–151. [Google Scholar] [CrossRef]
- Fazolin, G.N.; Varca, G.H.C.; de Freitas, L.F.; Rokita, B.; Kadlubowski, S.; Lugão, A.B. Simultaneous Intramolecular Crosslinking and Sterilization of Papain Nanoparticles by Gamma Radiation. Radiat. Phys. Chem. 2020, 171, 108697. [Google Scholar] [CrossRef]
- Kowalski, G.; Witczak, M.; Kuterasiński, Ł. Structure Effects on Swelling Properties of Hydrogels Based on Sodium Alginate and Acrylic Polymers. Molecules 2024, 29, 1937. [Google Scholar] [CrossRef]
- Dolbow, J.; Fried, E.; Ji, H. Chemically Induced Swelling of Hydrogels. J. Mech. Phys. Solids 2004, 52, 51–84. [Google Scholar] [CrossRef]
- Tran, V.T.; Mredha, T.I.; Pathak, S.K.; Yoon, H.; Cui, J.; Jeon, I. Conductive Tough Hydrogels with a Staggered Ion-Coordinating Structure for High Self-Recovery Rate. ACS Appl. Mater. Interfaces 2019, 11, 24598–24608. [Google Scholar] [CrossRef]
- Waham Ashaier Laftah, S.H.; Ibrahim, A.N. Polymer Hydrogels: A Review. Polym. Plast. Technol. Eng. 2011, 50, 1475–1486. [Google Scholar] [CrossRef]
- Redy Keisar, O.; Nahum, V.; Yehezkel, L.; Marcovitch, I.; Columbus, I.; Fridkin, G.; Chen, R. Active and Strippable PVA/Borax/NaBO3 Hydrogel for Effective Containment and Decontamination of Chemical Warfare Agents. ACS Omega 2021, 6, 5359–5367. [Google Scholar] [CrossRef] [PubMed]
- Niu, B.; Jia, J.; Wang, H.; Chen, S.; Cao, W.; Yan, J.; Gong, X.; Lian, X.; Li, W.; Fan, Y.-Y. In Vitro and in Vivo Release of Diclofenac Sodium-Loaded Sodium Alginate/Carboxymethyl Chitosan-ZnO Hydrogel Beads. Int. J. Biol. Macromol. 2019, 141, 1191–1198. [Google Scholar] [CrossRef] [PubMed]
- Golafshan, N.; Rezahasani, R.; Tarkesh Esfahani, M.; Kharaziha, M.; Khorasani, S.N. Nanohybrid Hydrogels of Laponite: PVA-Alginate as a Potential Wound Healing Material. Carbohydr. Polym. 2017, 176, 392–401. [Google Scholar] [CrossRef] [PubMed]
- Tao, L.; Shi, C.; Zi, Y.; Zhang, H.; Wang, X.; Zhong, J. A Review on the Chemical Modification of Alginates for Food Research: Chemical Nature, Modification Methods, Product Types, and Application. Food Hydrocoll. 2024, 147, 109338. [Google Scholar] [CrossRef]
- Mukherjee, K.; Dutta, P.; Saha, A.; Dey, S.; Sahu, V.; Badwaik, H.; Giri, T.K. Alginate Based Semi-IPN and IPN Hydrogel for Drug Delivery and Regenerative Medicine. J. Drug Deliv. Sci. Technol. 2024, 92, 105402. [Google Scholar] [CrossRef]
- Haryanto; Singh, D.; Han, S.S.; Son, J.H.; Kim, S.C. Poly(Ethylene Glycol) Dicarboxylate/Poly(Ethylene Oxide) Hydrogel Film Co-Crosslinked by Electron Beam Irradiation as an Anti-Adhesion Barrier. Mater. Sci. Eng. C 2015, 46, 195–201. [Google Scholar] [CrossRef]
- Kopka, B.; Kost, B.; Rajkowska, K.; Pawlak, A.; Kunicka-Styczyńska, A.; Biela, T.; Basko, M. A Simple Strategy for Efficient Preparation of Networks Based on Poly(2-Isopropenyl-2-Oxazoline), Poly(Ethylene Oxide), and Selected Biologically Active Compounds: Novel Hydrogels with Antibacterial Properties. Soft Matter 2021, 17, 10683–10695. [Google Scholar] [CrossRef]
- Aizaz, A.; Nawaz, M.H.; Ismat, M.S.; Zahid, L.; Zahid, S.; Ahmed, S.; Abbas, M.; Vayalpurayil, T.; Rehman, M.A.U. Development and Characterization of Polyethylene Oxide and Guar Gum-Based Hydrogel; a Detailed in-Vitro Analysis of Degradation and Drug Release Kinetics. Int. J. Biol. Macromol. 2024, 273, 132824. [Google Scholar] [CrossRef]
- Haryanto; Singh, D.; Huh, P.H.; Kim, S.C. Hyperbranched Poly(Glycidol)/Poly(Ethylene Oxide) Crosslinked Hydrogel for Tissue Engineering Scaffold Using e-Beams. J. Biomed. Mater. Res. A 2016, 104, 48–56. [Google Scholar] [CrossRef]
- Peters, J.T.; Wechsler, M.E.; Peppas, N.A. Advanced Biomedical Hydrogels: Molecular Architecture and Its Impact on Medical Applications. Regen. Biomater. 2021, 8, rbab060. [Google Scholar] [CrossRef] [PubMed]
- Erceg, T.; Vukić, N. Architecture of Hydrogels. In Hydrogels, Fundamentals to Advanced Energy Applications; CRC Press: Boca Raton, FL, USA, 2023; pp. 67–82. ISBN 9781003351566. [Google Scholar]
- Ghobashy, M.M.; Bassioni, G. PH Stimuli-Responsive Poly(Acrylamide-Co-Sodium Alginate) Hydrogels Prepared by γ-Radiation for Improved Compressive Strength of Concrete. Adv. Polym. Technol. 2018, 37, 2123–2133. [Google Scholar] [CrossRef]
- Bardajee, G.R.; Hooshyar, Z.; Zehtabi, F.; Pourjavadi, A. A Superabsorbent Hydrogel Network Based on Poly((2-Dimethylaminoethyl) Methacrylate) and Sodium Alginate Obtained by γ-Radiation: Synthesis and Characterization. Iran. Polym. J. 2012, 21, 829–836. [Google Scholar] [CrossRef]
- Hariharan, D.; Peppas, N.A. Characterization, Dynamic Swelling Behaviour and Solute Transport in Cationic Networks with Applications to the Development of Swelling-Controlled Release Systems. Polymer 1996, 37, 149–161. [Google Scholar] [CrossRef]
- Zaman, K.; Dahlan, M.; Hashim, K.; Ghazali, Z. The Application of Electron Accelerator: Liquid, Thin Film and Gases; Japan Atomic Energy Research Institute (JAERI): Chiba, Japan, 2004. [Google Scholar]
- Hashim, K.; Yacob, N. Radiation Processing of Sago Hydrogel Thin Film; Japan Atomic Energy Research Institute (JAERI): Chiba, Japan, 2004. [Google Scholar]
- Varaprasad, K.; Nùñez, D.; Ide, W.; Jayaramudu, T.; Sadiku, E.R. Development of High Alginate Comprised Hydrogels for Removal of Pb(II) Ions. J. Mol. Liq. 2020, 298, 112087. [Google Scholar] [CrossRef]
- Işık, B. Swelling Behavior and Determination of Diffusion Characteristics of Acrylamide–Acrylic Acid Hydrogels. J. Appl. Polym. Sci. 2004, 91, 1289–1293. [Google Scholar] [CrossRef]
- Yi, X.; Xu, Z.; Liu, Y.; Guo, X.; Ou, M.; Xu, X. Highly Efficient Removal of Uranium(vi) from Wastewater by Polyacrylic Acid Hydrogels. RSC Adv. 2017, 7, 6278–6287. [Google Scholar] [CrossRef]
- Pucić, I.; Jurkin, T. FTIR Assessment of Poly(Ethylene Oxide) Irradiated in Solid State, Melt and Aqeuous Solution. Radiat. Phys. Chem. 2012, 81, 1426–1429. [Google Scholar] [CrossRef]
- Nagasawa, N.; Yagi, T.; Kume, T.; Yoshii, F. Radiation Crosslinking of Carboxymethyl Starch. Carbohydr. Polym. 2004, 58, 109–113. [Google Scholar] [CrossRef]
- Karadag, E.; Saraydin, D.; Sahiner, N.; Güven, O. Radiation Induced Acrylamide/Citric Acid Hydrogels and Their Swelling Behaviors. J. Macromol. Sci. Part A 2001, 38, 1105–1121. [Google Scholar] [CrossRef]
- Yiamsawas, D.; Kangwansupamonkon, W.; Chailapakul, O.; Kiatkamjornwong, S. Synthesis and Swelling Properties of Poly[Acrylamide-Co-(Crotonic Acid)] Superabsorbents. React. Funct. Polym. 2007, 67, 865–882. [Google Scholar] [CrossRef]
- Ding, Z.Y.; Aklonis, J.J.; Salovey, R. Model Filled Polymers. VI. Determination of the Crosslink Density of Polymeric Beads by Swelling. J. Polym. Sci. B Polym. Phys. 1991, 29, 1035–1038. [Google Scholar] [CrossRef]
- Gudeman, L.F.; Peppas, N.A. PH-Sensitive Membranes from Poly(Vinyl Alcohol)/Poly(Acrylic Acid) Interpenetrating Networks. J. Membr. Sci. 1995, 107, 239–248. [Google Scholar] [CrossRef]
- Lee, B.H.; Li, B.; Guelcher, S.A. Gel Microstructure Regulates Proliferation and Differentiation of MC3T3-E1 Cells Encapsulated in Alginate Beads. Acta Biomater. 2012, 8, 1693–1702. [Google Scholar] [CrossRef]
- Liu, D.; Yang, M.; Wang, D.; Jing, X.; Lin, Y.; Feng, L.; Duan, X. DPD Study on the Interfacial Properties of PEO/PEO-PPO-PEO/PPO Ternary Blends: Effects of Pluronic Structure and Concentration. Polymers 2021, 13, 2866. [Google Scholar] [CrossRef]
- Chen, J.; Park, H.; Park, K. Synthesis of Superporous Hydrogels: Hydrogels with Fast Swelling and Superabsorbent Properties. J. Biomed. Mater. Res. 1999, 44, 53–62. [Google Scholar] [CrossRef]
- Üzüm, Ö.B.; Karadağ, E. A New Sorbent Chemically Cross-Linked Highly Swollen Copolymeric Hydrogels for Dye Uptake. Polym. Plast. Technol. Eng. 2006, 45, 1277–1283. [Google Scholar] [CrossRef]
- Peppas, N.A.; Franson, N.M. The Swelling Interface Number as a Criterion for Prediction of Diffusional Solute Release Mechanisms in Swellable Polymers. J. Polym. Sci. Polym. Phys. Ed. 1983, 21, 983–997. [Google Scholar] [CrossRef]
- Karadaǧ, E.; Üzüm, Ö.B.; Saraydin, D. Swelling Equilibria and Dye Adsorption Studies of Chemically Crosslinked Superabsorbent Acrylamide/Maleic Acid Hydrogels. Eur. Polym. J. 2002, 38, 2133–2141. [Google Scholar] [CrossRef]

| Solution Codes | Hydrogel Formulations | Diameter of Wet Hydrogels | Diameter and Height of Dry Hydrogels | Weight (g) | Density (g/cm3) | |
|---|---|---|---|---|---|---|
| Ø (mm) | Ø (mm) | h (mm) | ||||
| I-20 | I15-20 | 15 | 12.37 ± 0.18 | 1.41 ± 0.13 | 0.2377 ± 0.02 | 1.416 ± 0.023 |
| I10-20 | 10 | 7.61 ± 0.55 | 1.32 ± 0.24 | 0.0871 ± 0.03 | ||
| I7-20 | 7 | 5.15 ± 0.22 | 1.15 ± 0.08 | 0.0377 ± 0.01 | ||
| II-20 | II15-20 | 15 | 12.82 ± 0.35 | 1.30 ± 0.04 | 0.2032 ± 0.01 | 1.225 ± 0.013 |
| II10-20 | 10 | 8.89 ± 0.25 | 1.47 ± 0.12 | 0.1113 ± 0.01 | ||
| II7-20 | 7 | 5.51 ± 0.28 | 1.19 ± 0.15 | 0.0412 ± 0.01 | ||
| I-40 | I15-40 | 15 | 12.60 ± 0.45 | 3.41 ± 0.14 | 0.5093 ± 0.01 | 1.181 ± 0.034 |
| I10-40 | 10 | 8.09 ± 0.20 | 3.57 ± 0.10 | 0.2102 ± 0.01 | ||
| I7-40 | 7 | 5.24 ± 0.31 | 3.91 ± 0.29 | 0.0804 ± 0.01 | ||
| II-40 | II15-40 | 15 | 12.24 ± 0.42 | 3.41 ± 0.25 | 0.4983 ± 0.07 | 1.172 ± 0.092 |
| II10-40 | 10 | 8.38 ± 0.24 | 3.57 ± 0.03 | 0.2182 ± 0.04 | ||
| II7-40 | 7 | 5.90 ± 0.33 | 3.93 ± 0.20 | 0.1013 ± 0.01 | ||
| Code Samples | G (%) | ν2s × 10–3 (cm3) | Mc (kg/mol) | 10–3 (mol/cm3) | ξ (nm) | P (%) |
|---|---|---|---|---|---|---|
| I15-20 | 84.10 ± 0.09 | 9.36 ± 0.53 | 60.79 ± 5.85 | 1.22 ± 0.12 | 77.34 ± 5.19 | 98.49 ± 0.30 |
| I10-20 | 83.17 ± 4.09 | 5.52 ± 0.94 | 152.53 ± 43.35 | 0.34 ± 0.10 | 146.36 ± 29.24 | 99.30 ± 0.17 |
| I7-20 | 83.56 ± 0.32 | 3.27 ± 0.20 | 358.20 ± 36.56 | 0.21 ± 0.02 | 266.65 ± 19.03 | 99.51 ± 0.05 |
| I15-40 | 93.73 ± 0.63 | 21.08 ± 0.03 | 12.70 ± 0.03 | 5.83 ± 0.01 | 26.96 ± 0.04 | 97.52 ± 0.11 |
| I10-40 | 91.23 ± 0.22 | 12.87 ± 0.45 | 29.48 ± 1.75 | 2.51 ± 0.15 | 48.42 ± 2.00 | 98.51 ± 0.10 |
| I7-40 | 90.12 ± 0.17 | 9.09 ± 0.18 | 53.07 ± 1.74 | 1.39 ± 0.05 | 72.95 ± 1.67 | 98.95 ± 0.07 |
| II15-20 | 84.79 ± 0.08 | 10.62 ± 0.06 | 42.26 ± 0.43 | 1.78 ± 0.02 | 61.84 ± 0.43 | 98.67 ± 0.02 |
| II10-20 | 88.51 ± 0.85 | 7.80 ± 0.06 | 71.24 ± 0.93 | 1.05 ± 0.01 | 89.00 ± 0.81 | 99.08 ± 0.07 |
| II7-20 | 86.57 ± 3.94 | 4.60 ± 0.41 | 142.90 ± 19.37 | 0.43 ± 0.06 | 144.50 ± 13.70 | 99.40 ± 0.07 |
| II15-40 | 90.55 ± 0.49 | 16.49 ± 1.57 | 19.36 ± 3.13 | 3.93 ± 0.64 | 36.18 ± 4.08 | 97.83 ± 0.38 |
| II10-40 | 90.28 ± 0.39 | 12.91 ± 0.38 | 29.10 ± 1.46 | 2.58 ± 0.13 | 48.10 ± 1.68 | 98.55 ± 0.15 |
| II7-40 | 90.38 ± 0.26 | 10.18 ± 0.388 | 43.53 ± 2.78 | 1.73 ± 0.11 | 63.67 ± 2.83 | 98.84 ± 0.08 |
| Code Hydrogels | Smax. (%) | EWC (%) |
|---|---|---|
| I15-20 | 7489 ± 1232 | 98.52 ± 0.28 |
| I10-20 | 16,472 ± 2822 | 99.30 ± 0.17 |
| I7-20 | 20,441 ± 2204 | 99.51 ± 0.05 |
| I15-40 | 4040 ± 188 | 97.58 ± 0.11 |
| I10-40 | 6740 ± 449 | 98.53 ± 0.09 |
| I7-40 | 9580 ± 615 | 98.96 ± 0.06 |
| II15-20 | 7528 ± 132 | 98.69 ± 0.02 |
| II10-20 | 10,875 ± 856 | 99.09 ± 0.07 |
| II7-20 | 16,757 ± 2019 | 99.40 ± 0.07 |
| II15-40 | 4703 ± 791 | 97.88 ± 0.16 |
| II10-40 | 6949 ± 740 | 98.57 ± 0.14 |
| II7-40 | 8633 ± 615 | 98.85 ± 0.08 |
| Code | First-Order Rate Constants | Second-Order Rate Constants | ||||
|---|---|---|---|---|---|---|
| Seq. | ||||||
| I15-20 | 0.491 | 0.996 | 6.036 | 0.200 | 9093 | 0.993 |
| I10-20 | 0.371 | 0.995 | 1.543 | 0.145 | 21,142 | 0.994 |
| I7-20 | 0.291 | 0.986 | 0.747 | 0.156 | 29,272 | 0.977 |
| I15-40 | 0.304 | 0.992 | 3.744 | 0.832 | 5665 | 0.938 |
| I10-40 | 0.300 | 0.993 | 2.138 | 0.534 | 9354 | 0.901 |
| I7-40 | 0.379 | 0.978 | 2.392 | 0.271 | 12,410 | 0.959 |
| II15-20 | 0.517 | 0.991 | 5.875 | 0.222 | 8756 | 0.994 |
| II10-20 | 0.395 | 0.986 | 2.331 | 0.224 | 13,833 | 0.987 |
| II7-20 | 0.373 | 0.981 | 1.338 | 0.153 | 22,094 | 0.978 |
| II15-40 | 0.390 | 0.990 | 5.310 | 0.530 | 5960 | 0.972 |
| II10-40 | 0.400 | 0.986 | 3.567 | 0.373 | 8665 | 0.944 |
| II7-40 | 0.478 | 0.969 | 3.864 | 0.244 | 10,296 | 0.961 |
| Code | Swelling Diffusion | Diffusional Coefficient | |||
|---|---|---|---|---|---|
| n | k | R2 | D | R2 | |
| I15-20 | 0.788 | 0.128 | 0.994 | 2.346 | 0.995 |
| I10-20 | 0.834 | 0.160 | 0.997 | 2.787 | 0.989 |
| I7-20 | 0.745 | 0.291 | 0.996 | 1.095 | 0.994 |
| I15-40 | 0.695 | 0.080 | 0.996 | 0.206 | 0.998 |
| I10-40 | 0.686 | 0.138 | 0.994 | 0.199 | 0.998 |
| I7-40 | 0.611 | 0.401 | 0.989 | 0.223 | 0.995 |
| II15-20 | 0.680 | 0.264 | 0.997 | 1.474 | 0.990 |
| II10-20 | 0.743 | 0.196 | 0.985 | 1.134 | 0.999 |
| II7-20 | 0.704 | 0.369 | 0.988 | 0.931 | 0.999 |
| II15-40 | 0.659 | 0.148 | 0.997 | 0.343 | 0.999 |
| II10-40 | 0.607 | 0.310 | 0.991 | 0.272 | 0.994 |
| II7-40 | 0.538 | 0.704 | 0.979 | 0.225 | 0.992 |
| Solution Codes | Reagents/100 mL Solution (g) | Dose (kGy) | |||
|---|---|---|---|---|---|
| NaAlg | AAc | PEO | K2S2O8 | ||
| I | 0.5 | 20 | 0.1 | 0.1 | 12.5 |
| II | 1 | 20 | 0.1 | 0.1 | 12.5 |
| Solution Codes | Amounts (mL) (Petri Dish, Ø = 90 mm) | Film Thickness (mm) |
|---|---|---|
| I-20 | 20 | 1.53 ± 0.05 |
| II-20 | 1.88 ± 0.10 | |
| I-40 | 40 | 3.80 ± 0.21 |
| II-40 | 4.92 ± 0.07 |
Disclaimer/Publisher’s Note: The statements, opinions and data contained in all publications are solely those of the individual author(s) and contributor(s) and not of MDPI and/or the editor(s). MDPI and/or the editor(s) disclaim responsibility for any injury to people or property resulting from any ideas, methods, instructions or products referred to in the content. |
© 2024 by the authors. Licensee MDPI, Basel, Switzerland. This article is an open access article distributed under the terms and conditions of the Creative Commons Attribution (CC BY) license (https://creativecommons.org/licenses/by/4.0/).
Share and Cite
Călina, I.; Demeter, M.; Crăciun, G.; Scărișoreanu, A.; Mănăilă, E. The Influence of the Structural Architecture on the Swelling Kinetics and the Network Behavior of Sodium-Alginate-Based Hydrogels Cross-Linked with Ionizing Radiation. Gels 2024, 10, 588. https://doi.org/10.3390/gels10090588
Călina I, Demeter M, Crăciun G, Scărișoreanu A, Mănăilă E. The Influence of the Structural Architecture on the Swelling Kinetics and the Network Behavior of Sodium-Alginate-Based Hydrogels Cross-Linked with Ionizing Radiation. Gels. 2024; 10(9):588. https://doi.org/10.3390/gels10090588
Chicago/Turabian StyleCălina, Ion, Maria Demeter, Gabriela Crăciun, Anca Scărișoreanu, and Elena Mănăilă. 2024. "The Influence of the Structural Architecture on the Swelling Kinetics and the Network Behavior of Sodium-Alginate-Based Hydrogels Cross-Linked with Ionizing Radiation" Gels 10, no. 9: 588. https://doi.org/10.3390/gels10090588
APA StyleCălina, I., Demeter, M., Crăciun, G., Scărișoreanu, A., & Mănăilă, E. (2024). The Influence of the Structural Architecture on the Swelling Kinetics and the Network Behavior of Sodium-Alginate-Based Hydrogels Cross-Linked with Ionizing Radiation. Gels, 10(9), 588. https://doi.org/10.3390/gels10090588

